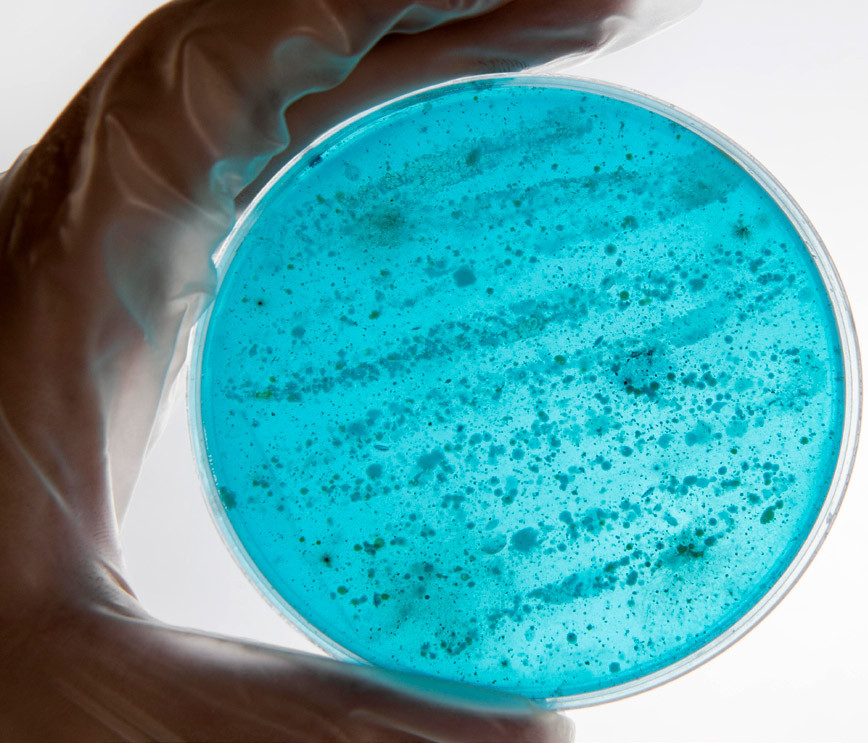

Санкт-Петербургский университетНаука
Раскодировать инфекцию
Когда стандартные методы диагностики не помогают идентифицировать возбудителя болезни, на помощь приходит анализ ДНК. Ученые СПбГУ разработали программу для обработки его результатов с учетом особенностей российского микробиома.
Каждый человек хотя бы раз в жизни делал анализ бактериальной флоры. Его назначают при различных инфекциях, чтобы точно определить патоген и начать прицельную терапию. Сегодня самыми популярными методами для изучения биоматериала считаются бактериальный посев в чашках Петри, иммуноферментный анализ и полимеразная цепная реакция (ПЦР), с которой все хорошо познакомились во время пандемии COVID-19.
К сожалению, у названных исследований есть ограничения. Не все бактерии можно вырастить в лабораторных условиях, а при взятии мазка для ПЦР в пробу может не попасть истинный возбудитель, тогда результат окажется недостоверным.
Если стандартные тесты не помогли понять, чем же заболел человек, врачи прибегают к секвенированию метагенома (набора геномов микроорганизмов). Это инновационный метод анализа микробного сообщества в биологических материалах на основе определения выделенной из образца последовательности ДНК. Секвенирование проводят разными методами, но суть у них одна. Сначала получают биоматериал (например, берут мазок). Далее «нарезают» ДНК в случайных местах и метят ее «штрихкодами», а затем в специальном приборе — секвенаторе — прочитывают каждый полученный участок.
«Благодаря метагеномному секвенированию можно выявлять бактерии, грибы, археи, паразиты и вирусы, а также оценивать устойчивость микроорганизмов к антибиотикам, уровень их патогенности и метаболический потенциал, то есть потребление, разложение и производство различных соединений», — рассказывает Павел Александрович Сучко, один из разработчиков, обучающийся 1-го курса магистратуры СПбГУ (программа «Биология»), биотехнолог центра геномных технологий «Сербалаб».
В настоящее время метагеномный анализ проводят только в частных лабораториях, крупных государственных научно-исследовательских институтах и медико-генетических центрах. При этом оперативная обработка метагенома бактериальных мазков — это довольно популярный запрос, а используемые для этого программы имеют ряд недостатков. В этом специалисты СПбГУ убедились на собственном опыте, так как работают в одном из российских центров геномных исследований.
Они поняли, что медицинское сообщество нуждается в новом инструменте, который бы полностью отвечал требованиям пользователей нашей страны и был лишен минусов существующих продуктов. Это подтолкнуло ученых СПбГУ к разработке своей программы. Благодаря тому, что в центре геномных технологий специалисты имели все необходимое для ее создания, появилась Antimicro. Она обрабатывает загруженные пользователем результаты секвенирования, а затем формирует заключение. В нем отражаются данные: например, о том, сколько бактерий и каких видов содержится в образце, а также какой у них уровень антибиотикорезистентности.
Ученые представили прототип программы на конкурсе «Start-up СПбГУ — 2025» и дошли до полуфинала.

Удобная и функциональная
Специалисты СПбГУ учли все недостатки конкурентов, в частности, сделали Antimicro полностью на русском языке. Сегодня большинство ее аналогов зарубежные, поэтому имеют иностранный интерфейс. Это снижает уровень удобства для русскоязычного пользователя и требует дополнительного времени для обучения работе в программе.
К тому же, по словам Лаврентия Глебовича Данилова, младшего научного сотрудника СПбГУ (кафедра генетики и биотехнологий), все платформы для обработки результатов секвенирования сложные, и случается, что даже врачу, владеющему иностранным языком, непросто понять, как они функционируют. Поэтому создатели Antimicro добавили в нее подробную инструкцию, чтобы даже неопытный пользователь сумел разобраться во всех ее функциях.
Если все-таки возникнут вопросы, всегда поможет техническая поддержка. Она у Antimicro оперативная, в отличие от конкурентов. Службы поддержки компаний — производителей других программ могут отвечать долго (например, из-за разницы во времени). Это увеличивает время диагностики и, как следствие, отсрочивает начало терапии. Для тех пациентов, которым требуется метагеномное секвенирование, обычно важен каждый час, поэтому даже небольшая задержка может быть для них опасна.
Кроме основного модуля для анализа метагенома, разработчики Antimicro предусмотрели несколько дополнительных, чего также нет в аналогах. В частности, справочник микроорганизмов, в котором врач может нажать на кнопку с изображением интересующей его бактерии, посмотреть, какие заболевания она потенциально способна вызвать у человека, чем их вылечить и какую назначить пробиотическую коррекцию. Еще ученые добавили справочник лекарственных средств и раздел для подбора терапии. С их помощью у специалиста есть возможность выбрать комбинацию препаратов, подобрать дозировку и схему приема.
Также исследователи позаботились о том, чтобы Antimicro учитывала популяционные отличия микробиома жителей России. «Все существующие аналоги нашей разработки созданы на зарубежных базах данных, которые не учитывают микробиологические особенности россиян. А ведь жители каждой страны отличаются друг от друга наличием тех или иных бактерий и их численностью. Когда мы анализируем микробиом российских жителей на основе данных о микрофлоре, например, граждан Китая, мы получаем неточный результат, — рассказывает Лаврентий Данилов. — До недавнего времени это была вынужденная мера, так как сведений о микробиоме нашей страны не было. Мы исправили ситуацию. В центре геномных исследований мы накопили достаточно информации для того, чтобы объединить ее в одну систему, отражающую микробиом населения России». В дальнейшем с появлением новых сведений база данных будет увеличиваться и обновляться.
Важно отметить, что программа Antimicro работает в так называемом закрытом контуре. Это значит, что данные о «микробиологическом паспорте» россиян надежно укрыты и не будут использованы в не медицинских целях.
Еще это открывает разработчикам возможность получить сертификат соответствия на медицинское изделие в Министерстве здравоохранения РФ. Сегодня такого сертификата нет ни у одной известной программы. Специалисты СПбГУ нацелены стать первыми, у кого он появится, чтобы Antimicro можно было включить в клинические рекомендации и использовать не только в частных лабораториях и клиниках, но и в государственных. В перспективе — включить в ОМС. Сертификация значительно расширит число тех, кто сможет пройти процедуру метагеномного секвенирования, и придаст выдаваемым Antimicro заключениям статус «официального медицинского документа». Их можно будет предъявлять в суде или на их основании получать дорогостоящие лекарства.
Много пользы
По словам Павла Сучко, Аntimicro получилась намного дешевле своих конкурентов. При этом для работы иностранных аналогов нужны большие компьютерные мощности. Аntimicro в этом не нуждается, ее можно установить на современный стационарный компьютер. Кстати, для каждой лаборатории разработчики готовы собрать свой «пакет» дополнительных модулей и максимально подстроить программу под выполняемые задачи. Такого обслуживания не предоставит ни один зарубежный поставщик.
Как рассказал Лаврентий Данилов, Аntimicro можно будет использовать в очень многих медицинских направлениях. Она будет полезна для инфекционистов, эпидемиологов, дерматологов, иммунологов, гастроэнтерологов, гинекологов, пульмонологов и даже онкологов. Так как для онкологических пациентов максимально важна эффективность химио- и иммунотерапии, что также зависит от состава микрофлоры.
«Разработка будет интересна лабораториям, предоставляющим услуги по молекулярной диагностике и метагеномному анализу, а также медицинским центрам, научно-исследовательским институтам и университетам», — отмечает Павел Сучко.
Благодаря Antimicro у врачей появится возможность спасать больше жизней и уменьшать проявления тяжелых хронических заболеваний, связанных с изменениями в микробиоме и приводящих к инвалидизации. Это поможет сохранить работоспособность большего количества людей и положительно скажется на экономической сфере России.
За счет удобства и невысокой цены у Antimicro есть шанс заменить собой все зарубежные аналоги. В этом случае лабораториям больше не придется закупать дорогостоящие платформы за рубежом, что также благоприятно отразится на экономике.
Кроме того, разработка ученых СПбГУ поможет России получить технологическую независимость в области обработки бактериального метагенома.
В ходе работы над платформой ученые поняли, что она станет полезна еще и в фармакологии, экологии, биотехнологии, сельском хозяйстве и пищевой промышленности. «В частности, с помощью Antimicro мы сможем выявлять, какие условия в биореакторе необходимы для более быстрого роста бактерий, которые потом могут быть использованы для производства витаминов, кисломолочных продуктов или хлеба», — подчеркивает Лаврентий Данилов.
Интересно
Самый популярный и надежный метод секвенирования — по Сэнгеру. Он позволяет «считывать» последовательности до 1000 пар оснований (п. о.) и используется для небольших фрагментов генома/генов или для валидации результатов более современного секвенирования нового поколения (next-generation sequencing, NGS), где размер одного прочитанного фрагмента варьирует от 25 до 500 п. о.
Впервые метод секвенирования по Сэнгеру был предложен Фредериком Сэнгером в 1977 году, за что он был удостоен Нобелевской премии по химии в 1980 году.
Источник: ru.wikipedia.org, biomolecula.ru
Команда Antimicro — участник конкурса «Start‑Up СПбГУ — 2025»
Павел Александрович Сучко, капитан команды, специалист в области лабораторной диагностики и биотехнологий, обучающийся 1-го курса магистратуры СПбГУ (программа «Биология»), биотехнолог центра геномных технологий «Сербалаб»;
Лаврентий Глебович Данилов, продакт-менеджер, кандидат биологических наук, младший научный сотрудник СПбГУ (кафедра генетики и биотехнологий), руководитель направления биоинформатики центра геномных технологий «Сербалаб»;
Дарья Алексеевна Некрасова, ведущий биоинформатик, кандидат фармацевтических наук, младший научный сотрудник департамента науки и подготовки научно-педагогических кадров Санкт-Петербургского государственного химико-фармацевтического университета.
Важно
До недавнего времени в мире не существовало базы данных о микробиоме россиян, поэтому результаты секвенирования анализировали, опираясь на микробиологические сведения о гражданах других стран. При этом жители каждого государства отличаются по наличию тех или иных бактерий, а также по их количеству. В центре геномных технологий ученые СПбГУ собрали информацию об особенностях микрофлоры жителей России. Исследователи сформировали информационную систему, которая содержит сведения о метагеноме (наборе генов) микроорганизмов более чем 600 человек. Также в нее вошли результаты анализов почти пяти тысяч человек, которые сделали секвенирование 16S рРНК (позволяет оценить состав микробиоты. — Прим. ред.). Исследователи продолжают пополнять базу данных.
Лаврентий Глебович Данилов, к. б. н., младший научный сотрудник СПбГУ (кафедра генетики и биотехнологий), руководитель направления биоинформатики центра геномных технологий «Сербалаб»
Павел Александрович Сучко, обучающийся 1-го курса магистратуры СПбГУ (программа «Биология»), биотехнолог центра геномных технологий «Сербалаб»
Фото: Предоставлено П. А. Сучко, предоставлено Л. Г. Даниловым
Хочешь стать одним из более 100 000 пользователей, кто регулярно использует kiozk для получения новых знаний?
Не упусти главного с нашим telegram-каналом: https://kiozk.ru/s/voyrl